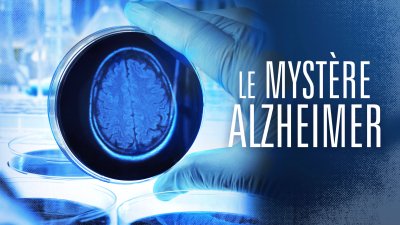

Adolescent
Je dis donc je suis
Alzheimer
Le Mystère Alzheimer
Amour
L’Amour à perpète
Apprentissage
Je dis donc je suis
Argumentation
Je dis donc je suis
Elève
Je dis donc je suis
Enfant
Entendre l’indicible
Enseigneùent
Je dis donc je suis
Etudiants
Viol, défi de justice
Femme
L’Amour à perpète
Hôpital
Entendre l’indicible
Jeunesse
Entendre l’indicible
Justice
Viol, défi de justice
Entendre l’indicible
Maladie
Le Mystère Alzheimer
Médecine
Le Mystère Alzheimer
Metoo
Viol, défi de justice

Parloir
L’Amour à perpète
Parole
Entendre l’indicible
Pédagogie
Je dis donc je suis
Prison
L’Amour à perpète
Procès
Viol, défi de justice
Psychologie
Entendre l’indicible
Santé
Le Mystère Alzheimer
Seine-Saint-Denis
Je dis donc je suis
Viol
Viol, défi de justice
Violence
Entendre l’indicible
